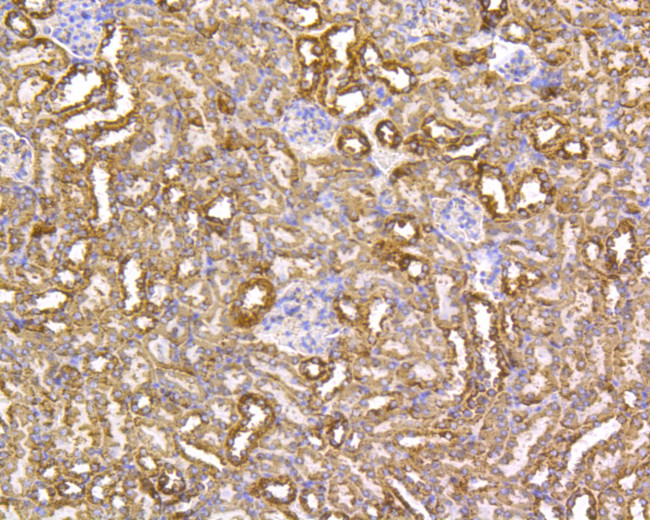
VDAC Antibody in Immunohistochemistry (Paraffin) (IHC (P))

Search
Invitrogen
VDAC Recombinant Rabbit Monoclonal Antibody (SA93-03)
{{$productOrderCtrl.translations['antibody.pdp.commerceCard.promotion.promotions']}}
{{$productOrderCtrl.translations['antibody.pdp.commerceCard.promotion.viewpromo']}}
{{$productOrderCtrl.translations['antibody.pdp.commerceCard.promotion.promocode']}}: {{promo.promoCode}} {{promo.promoTitle}} {{promo.promoDescription}}. {{$productOrderCtrl.translations['antibody.pdp.commerceCard.promotion.learnmore']}}
图: 1 / 8
VDAC Antibody (MA5-41088) in IHC (P)








Please note: We are reviewing Western blot images included in the antibody testing data in our catalog, including those provided by third parties. Unless expressly labeled or annotated as “raw-unedited”, Western blot images included in the antibody testing data in our catalog may have been edited, optimized or otherwise adjusted for presentation.
产品信息
MA5-41088
种属反应
宿主/亚型
Expression System
分类
类型
克隆号
抗原
偶联物
形式
浓度
规格
纯化类型
保存液
内含物
保存条件
运输条件
RRID
靶标信息
Voltage-dependent anion channel (VDAC) proteins are abundant, pore-forming proteins belonging to the eukaryotic mitochondrial porins. It was discovered in the mitochondrial outer membrane. It also is expressed in the plasma membrane. At least three different VDAC genes have been identified in vertebrates. VDAC proteins are known to play an essential role in cellular metabolism and in the early stages of apoptosis. For example, VDAC constitutes a major pathway by which metabolites such as ADP/ATP, succinate and citrate are exchanged between the cytosol and mitochondria. And VDAC1 in the plasma membrane establishes a novel level of apoptosis regulation putatively via its redox activity.
仅用于科研。不用于诊断过程。未经明确授权不得转售。
篇参考文献 (0)
生物信息学
蛋白别名: ARABIDOPSIS THALIANA VOLTAGE DEPENDENT ANION CHANNEL 1; ARABIDOPSIS THALIANA VOLTAGE DEPENDENT ANION CHANNEL 2; ATVDAC1; ATVDAC2; F2G14.210; HSR2; hVDAC1; K9I9.6; K9I9_6; MGC111064; Mitochondrial Porin; mVDAC1; mVDAC5; Non-selective voltage-gated ion channel VDAC1; Outer mitochondrial membrane protein porin 1; Plasmalemmal porin; Porin 31HL; Porin 31HM; PORIN-31-HL; rVDAC1; T22N4.9; T22N4_9; VD; VDAC-1; VDAC-5; VDAC1; VDAC2; Voltage-dependent anion-selective channel protein 1; Voltage-dependent anion-selective channel protein 5
基因别名: AL033343; VDAC; VDAC1; Vdac5
UniProt ID: (Mouse) Q60932, (Rat) Q9Z2L0
Entrez Gene ID: (Mouse) 22333, (Rat) 83529